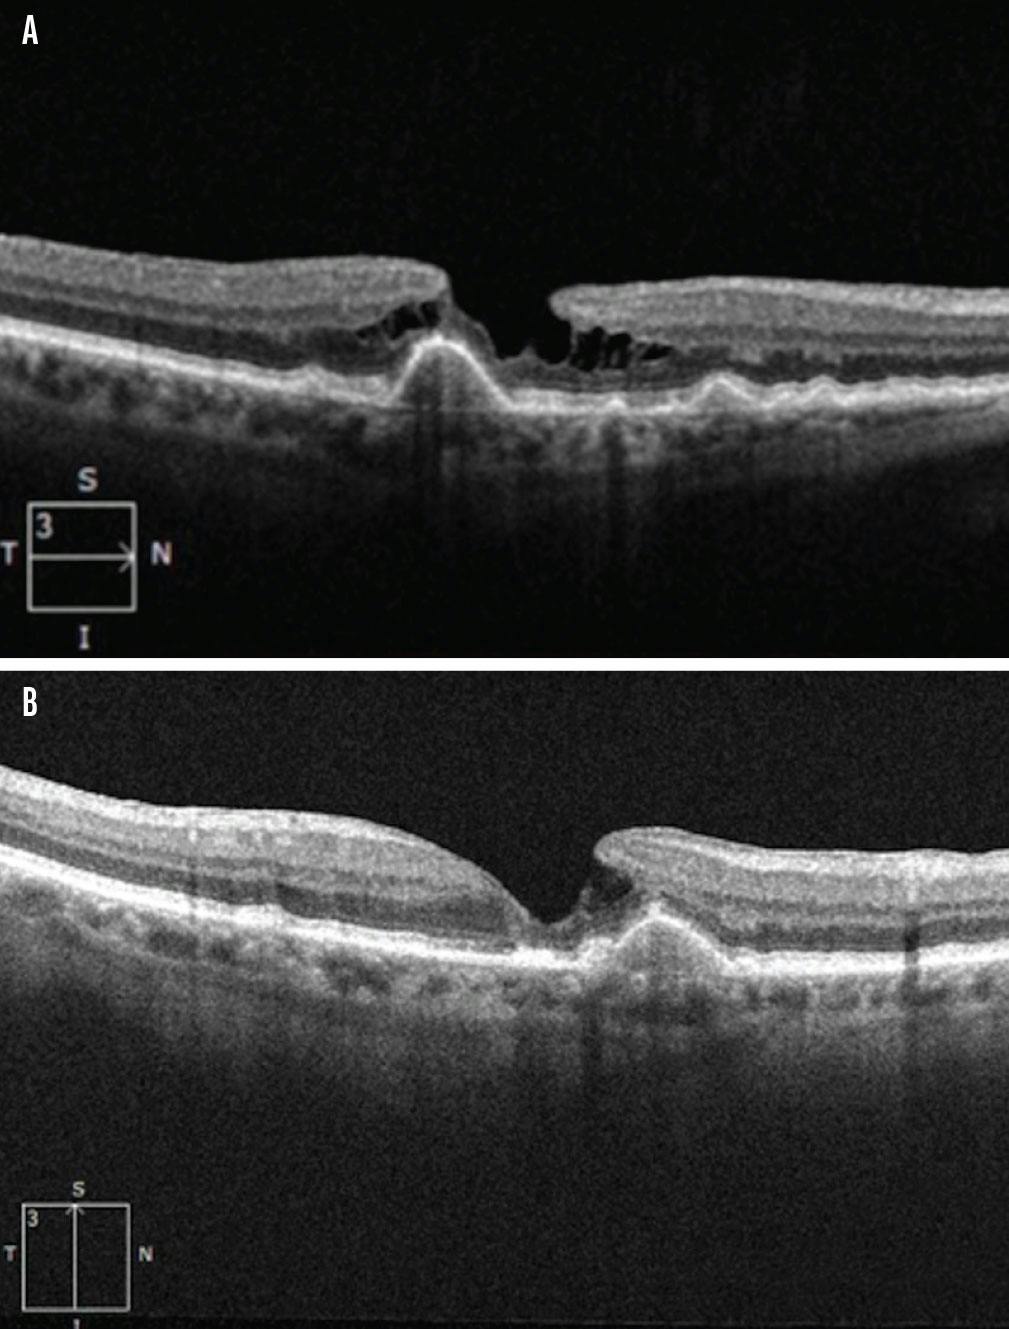

KEY TAKEAWAYS
- Based on its characteristics and presentation on OCT, a full-thickness macular hole (FTMH) may resolve without vitrectomy, suggesting initial observation may be prudent in select cases.
- Characteristics of FTMH that may suggest spontaneous closure include epiretinal proliferation (EP) and drusenoid deposits seen on OCT.
- In this case, the patient demonstrated EP based on the homogenous material of medium reflectivity anterior to the retinal nerve fiber layer, which seems to have aided in FTMH closure.
Visual deterioration due to an untreated full-thickness macular hole (FTMH) impairs quality of life for many patients. Surgical intervention is the mainstay treatment for most FTMHs; Tognetto et al found that vitrectomy performed less than 6 months from presentation leads to better anatomic outcomes and visual improvement.1 Moreover, it is commonly believed that late intervention is a risk factor for surgical failure; thus, many retina specialists tend to intervene earlier rather than later.
The spontaneous closure rate for a stage 2 MH has been reported as 11.4%, with the rates for stage 3 and stage 4 being closer to 4%, suggesting spontaneous closure is infrequent.2 However, based on its characteristics and presentation on OCT, a FTMH may resolve without vitrectomy. Various factors contribute to spontaneous closure, such as the stage of the MH, size or presence of bridging retinal tissue, epiretinal membrane, underlying pathogenesis, and vitreomacular traction (VMT). Spontaneous closure of a FTMH has also been described in patients with juxtafoveal telangiectasis (JXT),3 as well as in patients with epiretinal proliferation (EP).4
Our case study shows closure of a FTMH in the presence of EP and intermediate dry AMD with subsequent atrophy, suggesting clinicians should consider close observation for FTMH, depending on OCT characteristics.

Figure 1. On SD-OCT at initial presentation, both the horizontal (A) and vertical (B) scan through the fovea showed a FTMH with EP and underlying drusen without subretinal fluid in the patient’s right eye.
CASE REPORT
A 74-year-old man with hypertension, hyperlipidemia, and arthritis presented to the clinic for a 4-week follow-up appointment for blurred vision and floaters in the right eye. On examination, his BCVA was 20/50 OD. A dilated fundus examination of his right eye showed a posterior vitreous detachment, retinal arteriovenous nicking, a new FTMH, and many large drusen without hemorrhage.
Spectral-domain OCT (SD-OCT) illustrated EP and a FTMH with underlying drusen without subretinal fluid in his right eye (Figure 1). SD-OCT performed 45 days later illustrated resolution of the FTMH (Figure 2). One year after initial presentation with the FTMH, SD-OCT demonstrated collapse of the temporal and superior drusen along with outer retinal atrophy (Figure 3). It’s worth noting that with the outer retinal atrophy, the retinal pigment epithelium (RPE) appears to remain intact in the locations of drusen collapse. Sequentially tracked SD-OCT, obtained over the following 4 years, continued to demonstrate resolution without recurrence of the FTMH. The patient’s final VA was 20/80-1 OD.
Figure 2. Forty-five days after initial presentation, the horizontal (A) and vertical (B) scans through the fovea showed resolution of the FTMH with persistent subfoveal drusen.

Figure 3. One year after initial presentation, the horizontal (A) and vertical (B) scans through the fovea showed continued resolution of the FTMH, as well as outer retinal atrophy and collapse of previous drusen.
CONDITIONS FOR SPONTANEOUS CLOSURE
Spontaneous closure of a FTMH is uncommon, with a rate between 0% and 6%.5 The average time for spontaneous closure is about 3 months.6 The pathophysiology for spontaneous closure is not well understood, but Privat et al suggested the release of VMT may account for MH closure, which is also the reasoning behind performing vitrectomy.5 However, the patient in our case already had a posterior vitreous detachment at presentation and, therefore, no VMT, suggesting another etiology for closure.
The concept of spontaneous FTMH closure has been seen in other conditions, such as JXT. In JXT, it is believed that Müller cell degeneration causes neural retina loss and vascular abnormalities.3 Müller cells serve several important roles in the health of the retina, particularly structural integrity; therefore, Müller cell loss is thought to contribute to diminished structural support, leading to MH formation.7 Although Müller cells can contribute to macular hole formation, Bringmann et al suggests that residual or reactive Müller cells may paradoxically allow for spontaneous closure through glial proliferation and repair of foveal structure once tractional forces are relieved. The mechanism of this can be explained by bridging the gap in the inner portion of the central outer nuclear layer, forming a new inner Müller cell layer, and restoring the external limiting membrane.8
EP may have also played a role in our case. While EP is not completely understood, it may be due to Müller cell proliferation and migration from the inner retinal layers, vitreous components, and RPE cell proliferation and migration through ellipsoid zone defects.4,9 EP may be associated with weak contractile properties that may prevent FTMH closure.9 However, our patient demonstrated EP based on the homogenous material of medium reflectivity anterior to the retinal nerve fiber layer, which seems to have aided in FTMH closure.
Our case is accompanied by progressive collapse of drusen after hole closure. In the literature, there are four case reports and one case series of two patients with FTMH with either subfoveal soft drusen or pigmented epithelial detachment who underwent surgical closure of FTMH that also resulted in improvement or complete resolution of drusen and/or pigmented epithelial detachment.10 The resolution of the drusen following retina surgery is thought to be due to phagocytosis of drusen by macrophages that may be further enhanced by internal limiting membrane peeling.10
In our case, spontaneous resolution of the FTMH occurred with subsequent atrophy of the drusen. It has been speculated that eyes with outer retinal pathology (eg, AMD) might have a higher rate of EP formation.11 The relationship between drusen collapse, development of outer retinal atrophy (ie, incomplete RPE and complete RPE atrophy and outer retinal atrophy), EP, and FTMH is still unclear and should be evaluated further in the setting of intermediate AMD.
Lastly, topical therapies consisting of steroids, carbonic anhydrase inhibitors, and nonsteroidal antiinflammatory drugs have been used off-label for closure of MHs.12 These agents tend to work well for smaller MHs and in patients with little or no edema with a more than 50% success rate.12 The mechanism by which topical agents work is thought to involve decreasing macular edema, leading to closure of the hole by bringing the edges together.12 As our patient did not have any macular edema or subretinal fluid, had relatively preserved vision, and demonstrated MH closure during subsequent follow-up visits, further treatment has not been pursued. However, topical agents remain a reasonable option to consider for smaller holes with minimal or absent edema and relatively preserved vision, particularly before considering more invasive intervention.
TAKE STOCK OF OCT FINDINGS
The current treatment for FTMH is vitreoretinal surgery, but certain circumstances may lead FTMHs to resolve spontaneously, suggesting initial observation may be prudent in such cases. Characteristics of FTMH that may suggest spontaneous closure include EP and drusenoid deposits seen on OCT. More research is needed to evaluate the course of FTMH in this setting.
1. Tognetto D, Grandin R, Sanguinetti G, et al. Internal limiting membrane removal during macular hole surgery: results of a multicenter retrospective study. Ophthalmology. 2006;113(8):1401-1410.
2. Ullrich S, Haritoglou C, Gass C, Schaumberger M, Ulbig MW, Kampik A. Macular hole size as a prognostic factor in macular hole surgery. Br J Ophthalmol. 2002;86(4):390-393.
3. Nalcı H, Batıoğlu F, Demirel S, Özmert E. Spontaneous closure of macular hole in a patient with macular telangiectasia type 2. Retin Cases Brief Rep. 2021;15(4):369-372.
4. Pang CE, Maberley DA, Freund KB, et al. Lamellar hole-associated epiretinal proliferation: a clinicopathologic correlation. Retina. 2016;36(7):1408-1412.
5. Privat E, Tadayoni R, Gaucher D, Haouchine B, Massin P, Gaudric A. Residual defect in the foveal photoreceptor layer detected by optical coherence tomography in eyes with spontaneously closed macular holes. Am J Ophthalmol. 2007;143(5):814-819.
6. Liang X, Liu W. Characteristics and risk factors for spontaneous closure of idiopathic full-thickness macular hole. J Ophthalmol. 2019:2019:4793764.
7. Karth PA, Raja SC, Brown DM, Kim JE. Outcomes of macular hole surgeries for macular telangiectasia type 2. Retina. 2014;34(5):907-915.
8. Bringmann A, Duncker T, Jochmann C, Barth T, Duncker GIW, Wiedemann P. Spontaneous closure of small full-thickness macular holes: presumed role of Müller cells. Acta Ophthalmol. 2020;98:e447-e456.
9. Lee Kim E, Weiner AJ, Ung C, et al. Characterization of epiretinal proliferation in full-thickness macular holes and effects on surgical outcomes. Ophthalmol Retina. 2019;3(8):694-702.
10. Agarwal M, Muralidhar A, Singh S. Collapse of drusenoid pigment epithelial detachment following macular hole surgery: a case report. Indian J Ophthalmol. 2023;3(2):419-422.
11. Pang CE, Spaide RF, Freund KB. Comparing functional and morphologic characteristics of lamellar macular holes with and without lamellar hole-associated epiretinal proliferation. Retina. 2015;35(4):720-726.
12. Small KW, Avetisjan J, Shaya FS. Closure of macular holes with topical therapy. J Vitreoretin Dis. 2022;7(2):109-115.






_1773249222.png?auto=compress,format&w=70)







_1773249222.png?auto=compress,format&w=75)










